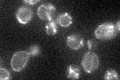
YDL044C
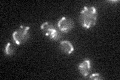
YDL044C

View description
Mitochondrial matrix protein that interacts with an N-terminal region of mitochondrial RNA polymerase (Rpo41p) and couples RNA processing and translation to transcription
Localization:
Intensity:
Fold change:
Significance:
-
C’ GFP library in SD
mitochondria29.67 -
N' NOP1pr-GFP in SD

mitochondria76.956 -
N' TEF2pr-mCherry in SD

mitochondria84.5941 -
N' NATIVEpr-GFP in SD

mitochondria104.768 -
N' TEF2pr-VC and Cyto-VN in SD

#N/A0 -
C’ GFP library in SD+DTT

mitochondria28.610.96No -
C’ GFP library in SD+H2O2

mitochondria30.661.03No -
C’ GFP library in Starvation Media
mitochondria29.260.98No -
C’ GFP library on the background of Pup2-DaMP

mitochondria -
C’ GFP library on the background of CCT mutant

mitochondria30.67081.03352No
